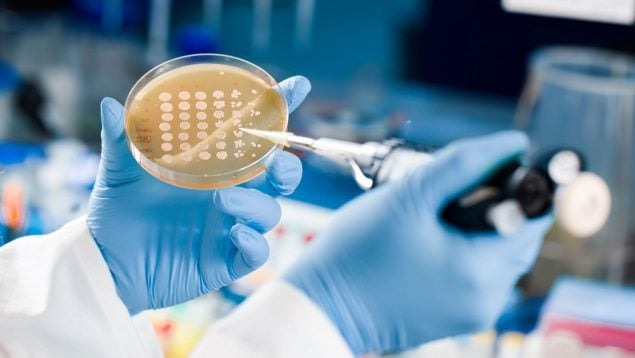

La prescripción de medicinas por enfermeros amplía sus competencias en 10 ámbitos clave de la sanidad
Diego Buenosvinos| 02.09.2024 La prescripción enfermera es una realidad que ha cobrado fuerza en los últimos años, permitiendo a los profesionales de enfermería prescribir medicamentos y productos sanitarios en situaciones específicas. Esta expansión de competencias...
Madrid inicia un programa pionero para administrar tratamientos oncológicos en el domicilio
Diego Buenosvinos | 3o.07.2024 La Comunidad de Madrid ha puesto en marcha en el Hospital público Universitario Gregorio Marañón un programa pionero en la región para la administración a domicilio de tratamientos oncológicos. Esta medida, que contribuye a mejorar la...
Tres nuevos medicamentos para luchar contra las «superbacterias» resistentes a los antibióticos
MÓNICA MORALES| 17.07.2024 Desde el descubrimiento de la penicilina por Alexander Fleming en 1928, los antibióticos han sido una de las herramientas más poderosas en la medicina para combatir infecciones bacterianas. Sin embargo, las bacterias no tardaron en...
Curso Mejorando la Toma de Decisiones en Oncología: Utilizando Endpoints Oncológicos Relevantes
BioPress | 22.06.2024 Curso Mejorando la Toma de Decisiones en Oncología: Utilizando Endpoints Oncológicos Relevantes Autor: Dr. JL Martin . Experto en Bioestadística Introducción Este curso tiene como objetivo equipar a los profesionales de la salud con una...

Comentarios